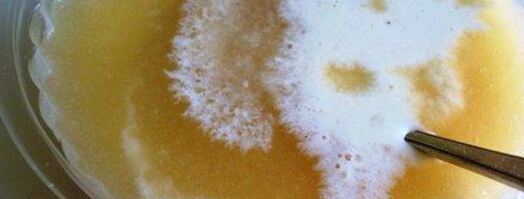
мороженое из дыни с медом. Шаг 5

Мороженое из дыни с медом
- Простой рецепт мороженого
- Время приготовления: 12 ч
- Порций: 2
- Калорий: 148 ккал
- Рецепт американской кухни
- Способ приготовления: Замораживать, охлаждать
- Повод: Завтрак, Обед, Полдник, Ужин, 8 Марта, День влюбленных, Детский праздник, Семейный праздник, 23 февраля
Невероятно вкусный десерт. Саму дыню я, конечно, съела без ничего, но много ее не съешь сами знаете. И вот нашла такой рецепт на американском сайте. Мне очень понравилось сочетание ингредиентов, и сама я точно ни за чтобы не догадалась насыпать в мороженое соли. Пробуйте=)
Любите готовить мороженое? Попробуйте рецепт мороженого дава. Должно понравиться.

Фото мороженого иза дынь с медома.
Приготовление
-
Дыню очистить от кожуры
-
Разрезать дыню на мелкие кусочки

-
Пюрировать ручным блендером

-
Теперь нужно подсластить по личному вкусу. Если мед находится в твердом состоянии или кристаллизуется, нужно растопить банку в миске с теплой водой, пока он не станет жидким снова. Таким образом, мед будет легко смешиваться с пюре из дыни. Начать путем смешивания с ложки меда. Если вы считаете, что смесь должна быть слаще, добавить еще мед. Имейте в виду, что мед должен выявить и дополнить вкус дыни, а не подавлять его.

-
Добавить сливки (молоко) и соль.

-
Налить мороженое в мороженицу (которой у меня нет) и заморозить в соответствии с инструкциями производителя. Однако, я периодически его помешивала от краев, повторяла несколько раз. Я замораживала ночь.

-
Но сам рецепт я посчитала обязательным рассказать вам. Потому что вкус у этого мороженого фантастический. Приятного аппетита!!=)

На заметку
Главное не опускать руки, тогда всё получится. Чаще готовьте, не теряйте форму. Советую мороженое из воска и пыльцы и сушеное яблоко с темным медом и бузиной. Всегда стараюсь приготовить что-нибудь новое.
Рецепт из коллекции: • Рецепты на ужин • Праздничные рецепты • Простые рецепты
Ингредиенты на
- дыня спелая 400 г
- мед жидкий 2 ст.л.
- сливки или молоко 100 мл
- соль 1 г
Мороженое
Очень вкусное домашнее мороженое! По вкусу похоже на магазинное, разница только в том, что домашнее мороженое готовится без всяких ненужных и вредных добавок....


Мороженое
Сладкоежкам рекомендуется посмотреть этот рецептик! Кто не любит мороженое? Перепробовал все сорта, а вот с дурианом еще никто не пробовал....
Мороженое
С наличием целого арсенала кухонной техники, кулинарный процесс стал намного проще для современных хозяек. Даже домашнее мороженое теперь не проблема. Его можно сделать по любому рецепту. Сегодня я предлагаю...


Мороженое
Если хочется полакомиться простым в приготовлении, но очень вкусным мороженым, то предлагаю приготовить мороженое с клюквой. Рецепт клюквенного мороженого очень прост и состоит всего из двух шагов....

Мороженое из гречки
Мороженое
Комментарии к рецепту
Спасибо, очень понравилось оформление мороженого из дыни с медом!
Всё сделала пошагово, следуя вашему рецепту.
Получилась вкуснятина!
Я сегодня нашла сайт случайно.
Я в таком восторге: понятные фото,пошаговые рецепты!
Обычно новое беру от свекрови, но теперь мне есть чем ее удивить, особенно оригинальность украшения.
А дети я знаю, будут в восторге!
Оказывается я только начинаю готовить.
Спасибо Вам!!!
Ни разу не пробовала творожное мороженое, но думаю, будет вкусно.
Отличный рецепт:)
Обожаю мороженое из дыни с медом
Спасибо, рецептик замечательный
Сегодня буду готовить!
Большое спасибо, доступно и все ясно.
Офигенно вкусно получается мороженое из дыни с медом и с первого раза!
спасибо большое!!!:)
Мороженое из кефира
Мороженое